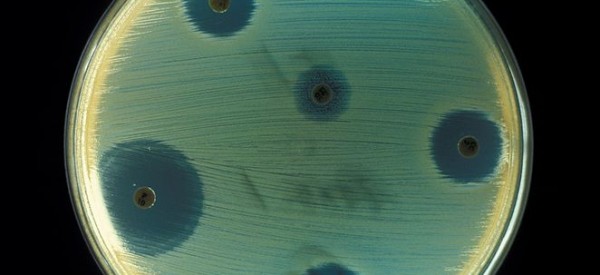

Robohand: How cheap 3D printers built a replacement hand for a five-year old boy | Ars Technica
Robohand: How cheap 3D printers built a replacement hand for a five-year old boy | Ars Technica.

Robohand: How cheap 3D printers built a replacement hand for a five-year old boy | Ars Technica.
Expert warning: Resistance to antibiotics to be apocalyptic.

Scientists propose creating Maxwell's demon with two quantum dots.

BlackBerry 10 launch analysis: first step in a long road | BGR.
Diamond defects shrink MRI to the nanoscale : Nature News & Comment.
Magnetic ratchet for three-dimensional spintronic memory and logic : Nature : Nature Publishing Group.
The Volatility of the Burgeoning 3D Printing Market > ENGINEERING.com.